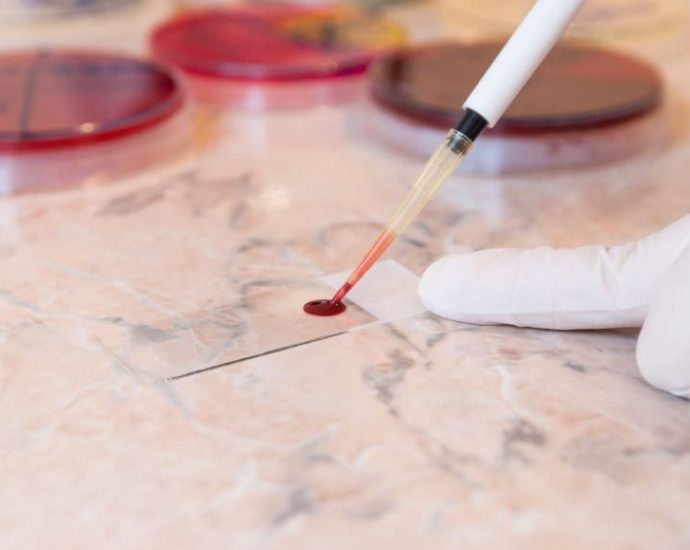

Only Half of Folks With Stool Test Positive for Colon Cancer Get Follow-Up Colonoscopy
MONDAY, Jan. 23, 2023 (HealthDay News) — Many people undergo a stool test to screen for colon cancer but a new study finds too few follow up with a colonoscopy when that test warns of a possible cancer. Not following up undermines the point of screening, said study-co-author Jeff Mohl,Continue Reading